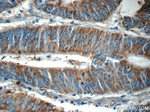
KLHL31 Antibody in Immunohistochemistry (Paraffin) (IHC (P))

Search
Proteintech
KLHL31 Polyclonal Antibody
{{$productOrderCtrl.translations['antibody.pdp.commerceCard.promotion.promotions']}}
{{$productOrderCtrl.translations['antibody.pdp.commerceCard.promotion.viewpromo']}}
{{$productOrderCtrl.translations['antibody.pdp.commerceCard.promotion.promocode']}}: {{promo.promoCode}} {{promo.promoTitle}} {{promo.promoDescription}}. {{$productOrderCtrl.translations['antibody.pdp.commerceCard.promotion.learnmore']}}
产品信息
24781-1-AP
种属反应
宿主/亚型
分类
类型
抗原
偶联物
形式
浓度
规格
纯化类型
保存液
内含物
保存条件
运输条件
产品详细信息
Immunogen sequence: MAPKKKIVK KNKGDINEMT IIVEDSPLNK LNALNGLLEG GNGLSCISSE LTDASYGPNL LEGLSKMRQE NFLCDLVIGT KTKSFDVHKS VMASCSEYFY NILKKDPSIQ RVDLNDISPL GLATVIAYAY TGKLTLSLYT IGSIISAAVY LQIHTLIKMC SDFLIREMSV ENCMYVVNIA ETYSLKNAKA AAQKFIRDNF LEFAESDQFM KLTFEQINEL LIDDDLQLPS EIVAFQIAMK WLEFDQKRVK YAADLLSNIR FGTISAQDLV NYVQSVPRMM QDADCHRLLV DAMNYHLLPY HQNTLQSRRT RIRGGCRVLV TVGGRPGLTE KSLSRDILYR DPENGWSKLT E (1-350 aa encoded by BC137267)
靶标信息
Transcriptional repressor in MAPK/JNK signaling pathway to regulate cellular functions. Overexpression inhibits the transcriptional activities of both the TPA-response element (TRE) and serum response element (SRE). [UniProt]
仅用于科研。不用于诊断过程。未经明确授权不得转售。
篇参考文献 (0)
生物信息学
蛋白别名: BTB and kelch domain-containing protein 6; kelch repeat and BTB (POZ) domain containing 1; Kelch repeat and BTB domain-containing protein 1; Kelch-like protein 31; Kelch-like protein KLHL
基因别名: 9830147P19Rik; bA345L23.2; BKLHD6; D930047P17Rik; KBTBD1; KLHL; KLHL31
UniProt ID: (Human) Q9H511, (Mouse) Q8BWA5
Entrez Gene ID: (Human) 401265, (Mouse) 244923